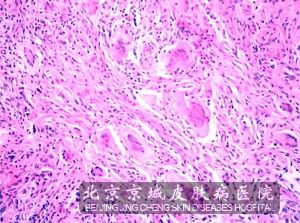

北京京城皮肤医院提供网络预约挂号服务
预约挂号热线:010-64888999
 三级专科
三级专科
 医保定点
医保定点
 舒适环境
舒适环境
 无假日
无假日
发疹性黄瘤有哪些病理改变?黄瘤病患者一般都会由于脂蛋白代谢异常,造成脂蛋白沉积在皮表,形成黄色瘤性的损害,有些损害位于眼睑部位,所以对于美观性影响较大。而有些则是位于躯干部位,为发疹性黄瘤。那么发疹性黄瘤有哪些病理改变?
发疹性黄瘤有哪些病理改变?黄瘤病患者一般都会由于脂蛋白代谢异常,造成脂蛋白沉积在皮表,形成黄色瘤性的损害,有些损害位于眼睑部位,所以对于美观性影响较大。而有些则是位于躯干部位,为发疹性黄瘤。那么发疹性黄瘤有哪些病理改变?
有关发疹性黄瘤有哪些病理改变,北京京城皮肤医院的介绍是这样的。
北京京城皮肤医院指出:发疹性黄瘤的病理改变主要就是 内有多数黄瘤、泡沫*,集合成结节状或弥散分布。而且多核黄瘤的核位于靠近*中央的位置,在外观看起来像是花环状,发疹性黄瘤较小,而淋巴*、中性粒*和嗜酸性*相对较多等改变。
以上是北京京城皮肤医院对于“发疹性黄瘤有哪些病理改变”的简单介绍。如果您想了解有关黄瘤病病理变化中重要以及一般病理的变化,请挂号专家获得。
推荐阅读:发疹性黄瘤有什么特征?
推荐阅读:发疹性黄瘤与其他黄瘤病的区别
推荐阅读:睑黄瘤的病发迹象